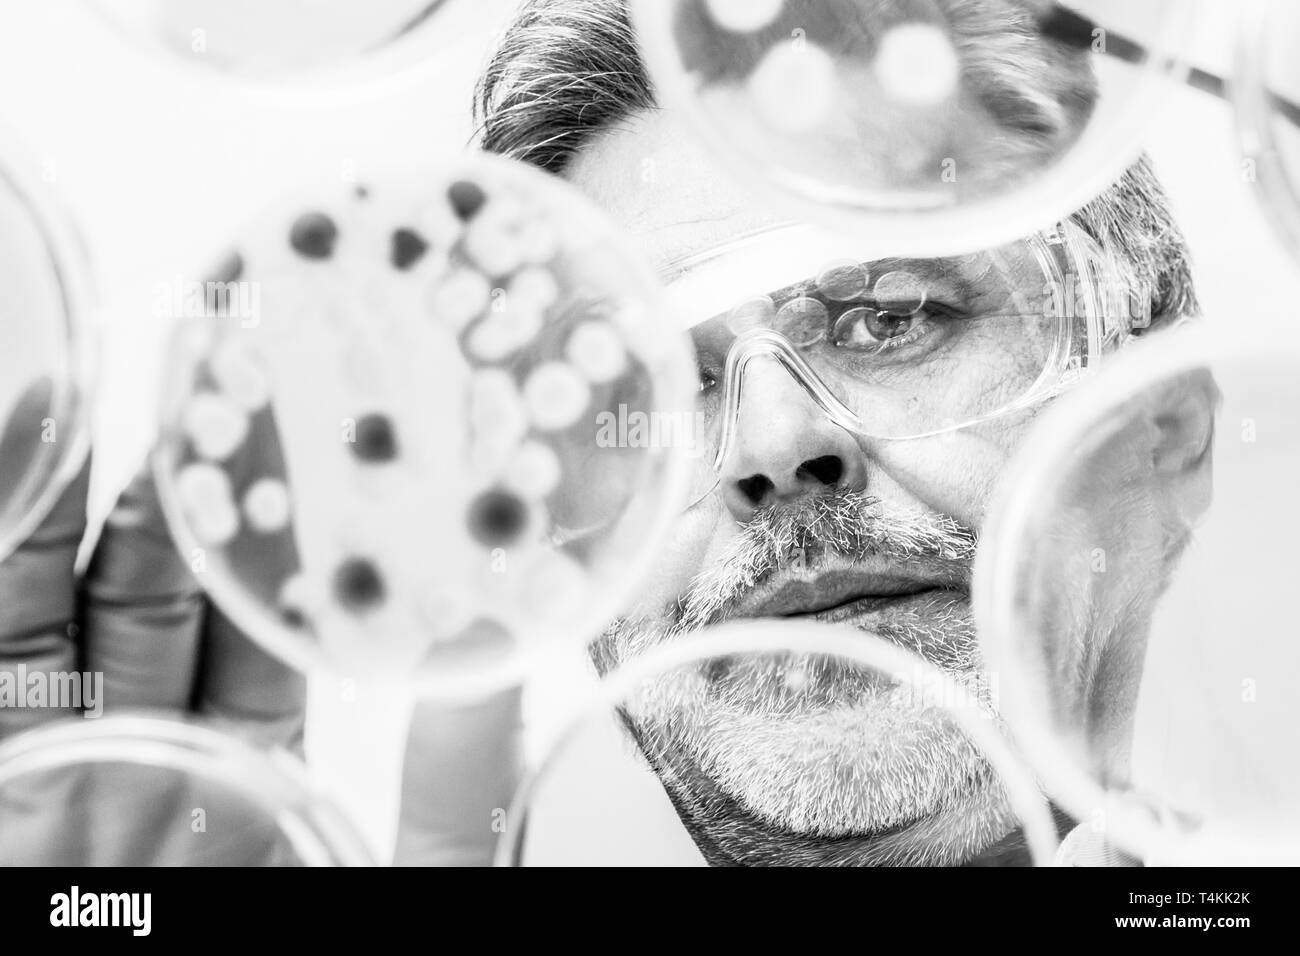
Chercheur en sciences de la vie des bactéries de greffage. Banque D'Images

Petri dish Banque de photos noir et blanc
(529)Petri dish Banque de photos noir et blanc
 Boîtes de Pétri Banque D'Imageshttps://www.alamyimages.fr/image-license-details/?v=1https://www.alamyimages.fr/boites-de-petri-image262056560.html
Boîtes de Pétri Banque D'Imageshttps://www.alamyimages.fr/image-license-details/?v=1https://www.alamyimages.fr/boites-de-petri-image262056560.htmlRFW69KPT–Boîtes de Pétri
 Chercheur en sciences de la vie l'observation de cellules dans la boîte de pétri. Banque D'Imageshttps://www.alamyimages.fr/image-license-details/?v=1https://www.alamyimages.fr/chercheur-en-sciences-de-la-vie-l-observation-de-cellules-dans-la-boite-de-petri-image212259068.html
Chercheur en sciences de la vie l'observation de cellules dans la boîte de pétri. Banque D'Imageshttps://www.alamyimages.fr/image-license-details/?v=1https://www.alamyimages.fr/chercheur-en-sciences-de-la-vie-l-observation-de-cellules-dans-la-boite-de-petri-image212259068.htmlRFP996H0–Chercheur en sciences de la vie l'observation de cellules dans la boîte de pétri.
 Boîte de Pétri avec les microbes, illustration de l'ordinateur. Image conceptuelle de diagnostic en laboratoire des maladies infectieuses. Banque D'Imageshttps://www.alamyimages.fr/image-license-details/?v=1https://www.alamyimages.fr/photo-image-boite-de-petri-avec-les-microbes-illustration-de-l-ordinateur-image-conceptuelle-de-diagnostic-en-laboratoire-des-maladies-infectieuses-133439760.html
Boîte de Pétri avec les microbes, illustration de l'ordinateur. Image conceptuelle de diagnostic en laboratoire des maladies infectieuses. Banque D'Imageshttps://www.alamyimages.fr/image-license-details/?v=1https://www.alamyimages.fr/photo-image-boite-de-petri-avec-les-microbes-illustration-de-l-ordinateur-image-conceptuelle-de-diagnostic-en-laboratoire-des-maladies-infectieuses-133439760.htmlRFHN2KNM–Boîte de Pétri avec les microbes, illustration de l'ordinateur. Image conceptuelle de diagnostic en laboratoire des maladies infectieuses.
 Petri isolated on white Banque D'Imageshttps://www.alamyimages.fr/image-license-details/?v=1https://www.alamyimages.fr/petri-isolated-on-white-image638894442.html
Petri isolated on white Banque D'Imageshttps://www.alamyimages.fr/image-license-details/?v=1https://www.alamyimages.fr/petri-isolated-on-white-image638894442.htmlRF2S3C4AJ–Petri isolated on white
 Boîte de Pétri Banque D'Imageshttps://www.alamyimages.fr/image-license-details/?v=1https://www.alamyimages.fr/boite-de-petri-image231975725.html
Boîte de Pétri Banque D'Imageshttps://www.alamyimages.fr/image-license-details/?v=1https://www.alamyimages.fr/boite-de-petri-image231975725.htmlRFRDBBB9–Boîte de Pétri
 Recherche cellulaire Banque D'Imageshttps://www.alamyimages.fr/image-license-details/?v=1https://www.alamyimages.fr/recherche-cellulaire-image475282001.html
Recherche cellulaire Banque D'Imageshttps://www.alamyimages.fr/image-license-details/?v=1https://www.alamyimages.fr/recherche-cellulaire-image475282001.htmlRF2JH6Y15–Recherche cellulaire
 Boîte de Pétri isolée sur fond blanc. Vide. 3d illustration. Banque D'Imageshttps://www.alamyimages.fr/image-license-details/?v=1https://www.alamyimages.fr/boite-de-petri-isolee-sur-fond-blanc-vide-3d-illustration-image505120913.html
Boîte de Pétri isolée sur fond blanc. Vide. 3d illustration. Banque D'Imageshttps://www.alamyimages.fr/image-license-details/?v=1https://www.alamyimages.fr/boite-de-petri-isolee-sur-fond-blanc-vide-3d-illustration-image505120913.htmlRF2M9P6TH–Boîte de Pétri isolée sur fond blanc. Vide. 3d illustration.
RF2D215TJ–Jeu d'icônes de ligne de coronavirus. On y a inclus des icônes comme virus, stéthoscope, contagieux, contagion, infection et plus encore.
 Verser du pétrole brut noir dans la boîte de Petri sur fond blanc Banque D'Imageshttps://www.alamyimages.fr/image-license-details/?v=1https://www.alamyimages.fr/verser-du-petrole-brut-noir-dans-la-boite-de-petri-sur-fond-blanc-image605780810.html
Verser du pétrole brut noir dans la boîte de Petri sur fond blanc Banque D'Imageshttps://www.alamyimages.fr/image-license-details/?v=1https://www.alamyimages.fr/verser-du-petrole-brut-noir-dans-la-boite-de-petri-sur-fond-blanc-image605780810.htmlRF2X5FKGX–Verser du pétrole brut noir dans la boîte de Petri sur fond blanc
RF2T96MAB–Icône de boîte de Pétri. Illustration vectorielle
 Macro de bactéries sur boîte de pétri isolé sur fond noir, la recherche scientifique ou la science concept pédagogiques, copy space Banque D'Imageshttps://www.alamyimages.fr/image-license-details/?v=1https://www.alamyimages.fr/photo-image-macro-de-bacteries-sur-boite-de-petri-isole-sur-fond-noir-la-recherche-scientifique-ou-la-science-concept-pedagogiques-copy-space-149755730.html
Macro de bactéries sur boîte de pétri isolé sur fond noir, la recherche scientifique ou la science concept pédagogiques, copy space Banque D'Imageshttps://www.alamyimages.fr/image-license-details/?v=1https://www.alamyimages.fr/photo-image-macro-de-bacteries-sur-boite-de-petri-isole-sur-fond-noir-la-recherche-scientifique-ou-la-science-concept-pedagogiques-copy-space-149755730.htmlRFJKHXXX–Macro de bactéries sur boîte de pétri isolé sur fond noir, la recherche scientifique ou la science concept pédagogiques, copy space
RF3B0FHRD–Moisissure fongique dans une boîte de Pétri, pénicilline médicale fongique, dessin stylisé à la main. Recherche sous microscope, macro monde de la moisissure. Icône, logo. Isolé sur w
 gouttes de gel transparentes dans une boîte de pétri isolées sur fond blanc. Recherche en laboratoire cosmétique, concept de test médical ou scientifique. Banque D'Imageshttps://www.alamyimages.fr/image-license-details/?v=1https://www.alamyimages.fr/gouttes-de-gel-transparentes-dans-une-boite-de-petri-isolees-sur-fond-blanc-recherche-en-laboratoire-cosmetique-concept-de-test-medical-ou-scientifique-image603630207.html
gouttes de gel transparentes dans une boîte de pétri isolées sur fond blanc. Recherche en laboratoire cosmétique, concept de test médical ou scientifique. Banque D'Imageshttps://www.alamyimages.fr/image-license-details/?v=1https://www.alamyimages.fr/gouttes-de-gel-transparentes-dans-une-boite-de-petri-isolees-sur-fond-blanc-recherche-en-laboratoire-cosmetique-concept-de-test-medical-ou-scientifique-image603630207.htmlRF2X21MDK–gouttes de gel transparentes dans une boîte de pétri isolées sur fond blanc. Recherche en laboratoire cosmétique, concept de test médical ou scientifique.
RF3B15KTD–Silhouette comme champignon moule dans la boîte de Pétri, chimie, biologie, médecine, recherche. Icône, logo. Isolé sur fond blanc. Illustration vectorielle
 Sérum liquide en flacon avec une pipette. Concept de soins de la peau avec escargot, sérum, boîte de Pétri, fougères, cotons-tiges, pipette. En noir et blanc. Banque D'Imageshttps://www.alamyimages.fr/image-license-details/?v=1https://www.alamyimages.fr/serum-liquide-en-flacon-avec-une-pipette-concept-de-soins-de-la-peau-avec-escargot-serum-boite-de-petri-fougeres-cotons-tiges-pipette-en-noir-et-blanc-image483173445.html
Sérum liquide en flacon avec une pipette. Concept de soins de la peau avec escargot, sérum, boîte de Pétri, fougères, cotons-tiges, pipette. En noir et blanc. Banque D'Imageshttps://www.alamyimages.fr/image-license-details/?v=1https://www.alamyimages.fr/serum-liquide-en-flacon-avec-une-pipette-concept-de-soins-de-la-peau-avec-escargot-serum-boite-de-petri-fougeres-cotons-tiges-pipette-en-noir-et-blanc-image483173445.htmlRF2K22CJD–Sérum liquide en flacon avec une pipette. Concept de soins de la peau avec escargot, sérum, boîte de Pétri, fougères, cotons-tiges, pipette. En noir et blanc.
 stades de croissance des bactéries vectorielles. cellules de bactéries noires dans des boîtes de petri isolées sur fond blanc Illustration de Vecteurhttps://www.alamyimages.fr/image-license-details/?v=1https://www.alamyimages.fr/stades-de-croissance-des-bacteries-vectorielles-cellules-de-bacteries-noires-dans-des-boites-de-petri-isolees-sur-fond-blanc-image342425903.html
stades de croissance des bactéries vectorielles. cellules de bactéries noires dans des boîtes de petri isolées sur fond blanc Illustration de Vecteurhttps://www.alamyimages.fr/image-license-details/?v=1https://www.alamyimages.fr/stades-de-croissance-des-bacteries-vectorielles-cellules-de-bacteries-noires-dans-des-boites-de-petri-isolees-sur-fond-blanc-image342425903.htmlRF2AW2RMF–stades de croissance des bactéries vectorielles. cellules de bactéries noires dans des boîtes de petri isolées sur fond blanc
 Elément branchy à manche vectoriel Illustration de Vecteurhttps://www.alamyimages.fr/image-license-details/?v=1https://www.alamyimages.fr/element-branchy-a-manche-vectoriel-image341971504.html
Elément branchy à manche vectoriel Illustration de Vecteurhttps://www.alamyimages.fr/image-license-details/?v=1https://www.alamyimages.fr/element-branchy-a-manche-vectoriel-image341971504.htmlRF2ATA440–Elément branchy à manche vectoriel
 Boîte de Pétri avec poudre de graphène, matériau léger, conducteur électrique, rigide et étanche. Banque D'Imageshttps://www.alamyimages.fr/image-license-details/?v=1https://www.alamyimages.fr/boite-de-petri-avec-poudre-de-graphene-materiau-leger-conducteur-electrique-rigide-et-etanche-image503424699.html
Boîte de Pétri avec poudre de graphène, matériau léger, conducteur électrique, rigide et étanche. Banque D'Imageshttps://www.alamyimages.fr/image-license-details/?v=1https://www.alamyimages.fr/boite-de-petri-avec-poudre-de-graphene-materiau-leger-conducteur-electrique-rigide-et-etanche-image503424699.htmlRF2M70Y9F–Boîte de Pétri avec poudre de graphène, matériau léger, conducteur électrique, rigide et étanche.
 Vue de dessus des compte-gouttes et des boîtes de Petri rondes avec des échantillons de laboratoire liquides sur une surface blanche pendant l'examen microscopique Banque D'Imageshttps://www.alamyimages.fr/image-license-details/?v=1https://www.alamyimages.fr/vue-de-dessus-des-compte-gouttes-et-des-boites-de-petri-rondes-avec-des-echantillons-de-laboratoire-liquides-sur-une-surface-blanche-pendant-l-examen-microscopique-image471787426.html
Vue de dessus des compte-gouttes et des boîtes de Petri rondes avec des échantillons de laboratoire liquides sur une surface blanche pendant l'examen microscopique Banque D'Imageshttps://www.alamyimages.fr/image-license-details/?v=1https://www.alamyimages.fr/vue-de-dessus-des-compte-gouttes-et-des-boites-de-petri-rondes-avec-des-echantillons-de-laboratoire-liquides-sur-une-surface-blanche-pendant-l-examen-microscopique-image471787426.htmlRF2JBFNJX–Vue de dessus des compte-gouttes et des boîtes de Petri rondes avec des échantillons de laboratoire liquides sur une surface blanche pendant l'examen microscopique
 La tuberculose Bacille de la culture. 1. Culture pure sur de solides dans le sérum sanguin, 2 tube à essai. Même dans une capsule de verre (une boîte de Pétri), mag. 700, 3. Même comme numéro deux, grossie 80, 4. Lamelle couvre-préparation des colonies, méthode d'Ehrlich. Heinrich Hermann Robert Koch (11 décembre 1843 - 27 mai 1910) était un médecin et microbiologiste allemand. Banque D'Imageshttps://www.alamyimages.fr/image-license-details/?v=1https://www.alamyimages.fr/la-tuberculose-bacille-de-la-culture-1-culture-pure-sur-de-solides-dans-le-serum-sanguin-2-tube-a-essai-meme-dans-une-capsule-de-verre-une-boite-de-petri-mag-700-3-meme-comme-numero-deux-grossie-80-4-lamelle-couvre-preparation-des-colonies-methode-d-ehrlich-heinrich-hermann-robert-koch-11-decembre-1843-27-mai-1910-etait-un-medecin-et-microbiologiste-allemand-image246624185.html
La tuberculose Bacille de la culture. 1. Culture pure sur de solides dans le sérum sanguin, 2 tube à essai. Même dans une capsule de verre (une boîte de Pétri), mag. 700, 3. Même comme numéro deux, grossie 80, 4. Lamelle couvre-préparation des colonies, méthode d'Ehrlich. Heinrich Hermann Robert Koch (11 décembre 1843 - 27 mai 1910) était un médecin et microbiologiste allemand. Banque D'Imageshttps://www.alamyimages.fr/image-license-details/?v=1https://www.alamyimages.fr/la-tuberculose-bacille-de-la-culture-1-culture-pure-sur-de-solides-dans-le-serum-sanguin-2-tube-a-essai-meme-dans-une-capsule-de-verre-une-boite-de-petri-mag-700-3-meme-comme-numero-deux-grossie-80-4-lamelle-couvre-preparation-des-colonies-methode-d-ehrlich-heinrich-hermann-robert-koch-11-decembre-1843-27-mai-1910-etait-un-medecin-et-microbiologiste-allemand-image246624185.htmlRMT96KJH–La tuberculose Bacille de la culture. 1. Culture pure sur de solides dans le sérum sanguin, 2 tube à essai. Même dans une capsule de verre (une boîte de Pétri), mag. 700, 3. Même comme numéro deux, grossie 80, 4. Lamelle couvre-préparation des colonies, méthode d'Ehrlich. Heinrich Hermann Robert Koch (11 décembre 1843 - 27 mai 1910) était un médecin et microbiologiste allemand.
RFPXHE41–Pétri de bactéries simple icône ligne. Signe et symbole illustration design. Isolé sur fond blanc
Chercheur en sciences de la vie des bactéries de greffage. Banque D'Imageshttps://www.alamyimages.fr/image-license-details/?v=1https://www.alamyimages.fr/chercheur-en-sciences-de-la-vie-des-bacteries-de-greffage-image243835835.html
Chercheur en sciences de la vie des bactéries de greffage. Banque D'Imageshttps://www.alamyimages.fr/image-license-details/?v=1https://www.alamyimages.fr/chercheur-en-sciences-de-la-vie-des-bacteries-de-greffage-image243835835.htmlRFT4KK2K–Chercheur en sciences de la vie des bactéries de greffage.
 Petri isolated on white Banque D'Imageshttps://www.alamyimages.fr/image-license-details/?v=1https://www.alamyimages.fr/petri-isolated-on-white-image640031349.html
Petri isolated on white Banque D'Imageshttps://www.alamyimages.fr/image-license-details/?v=1https://www.alamyimages.fr/petri-isolated-on-white-image640031349.htmlRF2S57XED–Petri isolated on white
 Laboratoire de sciences molécule bactéries petri Illustration de Vecteurhttps://www.alamyimages.fr/image-license-details/?v=1https://www.alamyimages.fr/laboratoire-de-sciences-molecule-bacteries-petri-image219691549.html
Laboratoire de sciences molécule bactéries petri Illustration de Vecteurhttps://www.alamyimages.fr/image-license-details/?v=1https://www.alamyimages.fr/laboratoire-de-sciences-molecule-bacteries-petri-image219691549.htmlRFPNBPPN–Laboratoire de sciences molécule bactéries petri
 Boîte de Petri isolée sur fond blanc. Boîte de Pétri isolée sur blanc Banque D'Imageshttps://www.alamyimages.fr/image-license-details/?v=1https://www.alamyimages.fr/boite-de-petri-isolee-sur-fond-blanc-boite-de-petri-isolee-sur-blanc-image638829808.html
Boîte de Petri isolée sur fond blanc. Boîte de Pétri isolée sur blanc Banque D'Imageshttps://www.alamyimages.fr/image-license-details/?v=1https://www.alamyimages.fr/boite-de-petri-isolee-sur-fond-blanc-boite-de-petri-isolee-sur-blanc-image638829808.htmlRF2S395X8–Boîte de Petri isolée sur fond blanc. Boîte de Pétri isolée sur blanc
 Boîte de Pétri isolée sur fond blanc. Vide. Vue de dessus. 3d illustration. Banque D'Imageshttps://www.alamyimages.fr/image-license-details/?v=1https://www.alamyimages.fr/boite-de-petri-isolee-sur-fond-blanc-vide-vue-de-dessus-3d-illustration-image505142829.html
Boîte de Pétri isolée sur fond blanc. Vide. Vue de dessus. 3d illustration. Banque D'Imageshttps://www.alamyimages.fr/image-license-details/?v=1https://www.alamyimages.fr/boite-de-petri-isolee-sur-fond-blanc-vide-vue-de-dessus-3d-illustration-image505142829.htmlRF2M9R6R9–Boîte de Pétri isolée sur fond blanc. Vide. Vue de dessus. 3d illustration.
RF2S6C671–boîte de petri avec vecteur d'icône glyphe de biopsie. boîte de pétri avec signe de biopsie. illustration noire du symbole de contour isolé. boîte de petri avec illustration vectorielle d'icône de glyphe de biopsie
 Verser du pétrole brut noir dans la boîte de Petri sur fond blanc Banque D'Imageshttps://www.alamyimages.fr/image-license-details/?v=1https://www.alamyimages.fr/verser-du-petrole-brut-noir-dans-la-boite-de-petri-sur-fond-blanc-image605780820.html
Verser du pétrole brut noir dans la boîte de Petri sur fond blanc Banque D'Imageshttps://www.alamyimages.fr/image-license-details/?v=1https://www.alamyimages.fr/verser-du-petrole-brut-noir-dans-la-boite-de-petri-sur-fond-blanc-image605780820.htmlRF2X5FKH8–Verser du pétrole brut noir dans la boîte de Petri sur fond blanc
 Laboratoire de sciences molécule bactéries petri Illustration de Vecteurhttps://www.alamyimages.fr/image-license-details/?v=1https://www.alamyimages.fr/laboratoire-de-sciences-molecule-bacteries-petri-image219225480.html
Laboratoire de sciences molécule bactéries petri Illustration de Vecteurhttps://www.alamyimages.fr/image-license-details/?v=1https://www.alamyimages.fr/laboratoire-de-sciences-molecule-bacteries-petri-image219225480.htmlRFPMJG9C–Laboratoire de sciences molécule bactéries petri
 Verser du pétrole brut noir dans la boîte de Petri sur fond blanc Banque D'Imageshttps://www.alamyimages.fr/image-license-details/?v=1https://www.alamyimages.fr/verser-du-petrole-brut-noir-dans-la-boite-de-petri-sur-fond-blanc-image601627879.html
Verser du pétrole brut noir dans la boîte de Petri sur fond blanc Banque D'Imageshttps://www.alamyimages.fr/image-license-details/?v=1https://www.alamyimages.fr/verser-du-petrole-brut-noir-dans-la-boite-de-petri-sur-fond-blanc-image601627879.htmlRF2WXPEDY–Verser du pétrole brut noir dans la boîte de Petri sur fond blanc
RFT5C2R1–Les bactéries, microbes, virus dans l'icône de la ligne de petri.
 Produit cosmétique en boîte de Pétri isolé sur blanc, vue de dessus Banque D'Imageshttps://www.alamyimages.fr/image-license-details/?v=1https://www.alamyimages.fr/produit-cosmetique-en-boite-de-petri-isole-sur-blanc-vue-de-dessus-image685577435.html
Produit cosmétique en boîte de Pétri isolé sur blanc, vue de dessus Banque D'Imageshttps://www.alamyimages.fr/image-license-details/?v=1https://www.alamyimages.fr/produit-cosmetique-en-boite-de-petri-isole-sur-blanc-vue-de-dessus-image685577435.htmlRF3BRAN0B–Produit cosmétique en boîte de Pétri isolé sur blanc, vue de dessus
RF2B889EW–virus covid 19 pandémique laboratoire boîte de petri analyse vectoriel illustration style icône
 Pipette en verre et boîte de Petri avec liquide sur fond blanc, vue de dessus Banque D'Imageshttps://www.alamyimages.fr/image-license-details/?v=1https://www.alamyimages.fr/pipette-en-verre-et-boite-de-petri-avec-liquide-sur-fond-blanc-vue-de-dessus-image605525706.html
Pipette en verre et boîte de Petri avec liquide sur fond blanc, vue de dessus Banque D'Imageshttps://www.alamyimages.fr/image-license-details/?v=1https://www.alamyimages.fr/pipette-en-verre-et-boite-de-petri-avec-liquide-sur-fond-blanc-vue-de-dessus-image605525706.htmlRF2X54262–Pipette en verre et boîte de Petri avec liquide sur fond blanc, vue de dessus
 Des bactéries dans des boîtes de Pétri. Banque D'Imageshttps://www.alamyimages.fr/image-license-details/?v=1https://www.alamyimages.fr/des-bacteries-dans-des-boites-de-petri-image243835914.html
Des bactéries dans des boîtes de Pétri. Banque D'Imageshttps://www.alamyimages.fr/image-license-details/?v=1https://www.alamyimages.fr/des-bacteries-dans-des-boites-de-petri-image243835914.htmlRFT4KK5E–Des bactéries dans des boîtes de Pétri.
 Boîte de Pétri avec poudre de carbonate de calcium et flacon de laboratoire sur table gris clair. Espace pour le texte Banque D'Imageshttps://www.alamyimages.fr/image-license-details/?v=1https://www.alamyimages.fr/boite-de-petri-avec-poudre-de-carbonate-de-calcium-et-flacon-de-laboratoire-sur-table-gris-clair-espace-pour-le-texte-image555809779.html
Boîte de Pétri avec poudre de carbonate de calcium et flacon de laboratoire sur table gris clair. Espace pour le texte Banque D'Imageshttps://www.alamyimages.fr/image-license-details/?v=1https://www.alamyimages.fr/boite-de-petri-avec-poudre-de-carbonate-de-calcium-et-flacon-de-laboratoire-sur-table-gris-clair-espace-pour-le-texte-image555809779.htmlRF2R87917–Boîte de Pétri avec poudre de carbonate de calcium et flacon de laboratoire sur table gris clair. Espace pour le texte
 Boîte de Pétri avec poudre de graphène, matériau léger, conducteur électrique, rigide et étanche. Banque D'Imageshttps://www.alamyimages.fr/image-license-details/?v=1https://www.alamyimages.fr/boite-de-petri-avec-poudre-de-graphene-materiau-leger-conducteur-electrique-rigide-et-etanche-image503424695.html
Boîte de Pétri avec poudre de graphène, matériau léger, conducteur électrique, rigide et étanche. Banque D'Imageshttps://www.alamyimages.fr/image-license-details/?v=1https://www.alamyimages.fr/boite-de-petri-avec-poudre-de-graphene-materiau-leger-conducteur-electrique-rigide-et-etanche-image503424695.htmlRF2M70Y9B–Boîte de Pétri avec poudre de graphène, matériau léger, conducteur électrique, rigide et étanche.
 Boîte de Pétri avec échantillon isolé sur blanc Banque D'Imageshttps://www.alamyimages.fr/image-license-details/?v=1https://www.alamyimages.fr/boite-de-petri-avec-echantillon-isole-sur-blanc-image617123013.html
Boîte de Pétri avec échantillon isolé sur blanc Banque D'Imageshttps://www.alamyimages.fr/image-license-details/?v=1https://www.alamyimages.fr/boite-de-petri-avec-echantillon-isole-sur-blanc-image617123013.htmlRF2XT0AKH–Boîte de Pétri avec échantillon isolé sur blanc
 Richard Petri, Richard Petri (1852 – 1921) microbiologiste allemand généralement crédité d'inventer le dispositif connu sous le nom de boîte de Petri Banque D'Imageshttps://www.alamyimages.fr/image-license-details/?v=1https://www.alamyimages.fr/richard-petri-richard-petri-1852-1921-microbiologiste-allemand-generalement-credite-d-inventer-le-dispositif-connu-sous-le-nom-de-boite-de-petri-image351884668.html
Richard Petri, Richard Petri (1852 – 1921) microbiologiste allemand généralement crédité d'inventer le dispositif connu sous le nom de boîte de Petri Banque D'Imageshttps://www.alamyimages.fr/image-license-details/?v=1https://www.alamyimages.fr/richard-petri-richard-petri-1852-1921-microbiologiste-allemand-generalement-credite-d-inventer-le-dispositif-connu-sous-le-nom-de-boite-de-petri-image351884668.htmlRM2BCDMDG–Richard Petri, Richard Petri (1852 – 1921) microbiologiste allemand généralement crédité d'inventer le dispositif connu sous le nom de boîte de Petri
RFKH8GC5–Pétri de bactéries simple icône ligne. symbole et signe la conception d'illustration vectorielle. isolé sur fond blanc
RF2SCTRE0–Illustration de conception d'icône de vecteur de Petri
 Chercheur en sciences de la vie des bactéries de greffage. Banque D'Imageshttps://www.alamyimages.fr/image-license-details/?v=1https://www.alamyimages.fr/chercheur-en-sciences-de-la-vie-des-bacteries-de-greffage-image243835811.html
Chercheur en sciences de la vie des bactéries de greffage. Banque D'Imageshttps://www.alamyimages.fr/image-license-details/?v=1https://www.alamyimages.fr/chercheur-en-sciences-de-la-vie-des-bacteries-de-greffage-image243835811.htmlRFT4KK1R–Chercheur en sciences de la vie des bactéries de greffage.
 boîte de petri pour illustration vectorielle de recherche chimique et biologique isolée sur fond blanc Banque D'Imageshttps://www.alamyimages.fr/image-license-details/?v=1https://www.alamyimages.fr/boite-de-petri-pour-illustration-vectorielle-de-recherche-chimique-et-biologique-isolee-sur-fond-blanc-image609507084.html
boîte de petri pour illustration vectorielle de recherche chimique et biologique isolée sur fond blanc Banque D'Imageshttps://www.alamyimages.fr/image-license-details/?v=1https://www.alamyimages.fr/boite-de-petri-pour-illustration-vectorielle-de-recherche-chimique-et-biologique-isolee-sur-fond-blanc-image609507084.htmlRF2XBHCE4–boîte de petri pour illustration vectorielle de recherche chimique et biologique isolée sur fond blanc
RF2DGA7BN–icône de boîte de petri, signe vectoriel noir avec traits modifiables, illustration du concept
RF2DD26YT–Icône linéaire de boîte de Pétri
RF2S6C62E–boîte de petri avec vecteur d'icône de ligne de biopsie. boîte de pétri avec signe de biopsie. illustration noire du symbole de contour isolé. boîte de petri avec illustration vectorielle d'icône de ligne de biopsie
 La recherche génétique Banque D'Imageshttps://www.alamyimages.fr/image-license-details/?v=1https://www.alamyimages.fr/la-recherche-genetique-image65212520.html
La recherche génétique Banque D'Imageshttps://www.alamyimages.fr/image-license-details/?v=1https://www.alamyimages.fr/la-recherche-genetique-image65212520.htmlRFDP2K6G–La recherche génétique
 Équipement scientifique vintage : microscope rétro de laboratoire et gravure de boîtes de Petri pour la conception éducative. Illustration de Vecteurhttps://www.alamyimages.fr/image-license-details/?v=1https://www.alamyimages.fr/equipement-scientifique-vintage-microscope-retro-de-laboratoire-et-gravure-de-boites-de-petri-pour-la-conception-educative-image700571084.html
Équipement scientifique vintage : microscope rétro de laboratoire et gravure de boîtes de Petri pour la conception éducative. Illustration de Vecteurhttps://www.alamyimages.fr/image-license-details/?v=1https://www.alamyimages.fr/equipement-scientifique-vintage-microscope-retro-de-laboratoire-et-gravure-de-boites-de-petri-pour-la-conception-educative-image700571084.htmlRF3CKNNFT–Équipement scientifique vintage : microscope rétro de laboratoire et gravure de boîtes de Petri pour la conception éducative.
RF2C54M8E–boîte de pétri sang soins médicaux et hôpital pictogramme style silhouette icône illustration vecteur
RFT9WYYA–Ensemble d'icônes de ligne de bactéries. Microbe, germe, Caviar, cellules du système immunitaire, et plus encore.
RF3BPFTWT–Une icône de dépôt d'échantillon dans un style minimaliste avec un trait modifiable. Pipette de laboratoire, boîte de Petri, test liquide, échantillon clinique, analyse médicale, biologie
 Vue de dessus des compte-gouttes et des boîtes de Petri rondes avec des échantillons de laboratoire liquides sur une surface blanche pendant l'examen microscopique Banque D'Imageshttps://www.alamyimages.fr/image-license-details/?v=1https://www.alamyimages.fr/vue-de-dessus-des-compte-gouttes-et-des-boites-de-petri-rondes-avec-des-echantillons-de-laboratoire-liquides-sur-une-surface-blanche-pendant-l-examen-microscopique-image487175275.html
Vue de dessus des compte-gouttes et des boîtes de Petri rondes avec des échantillons de laboratoire liquides sur une surface blanche pendant l'examen microscopique Banque D'Imageshttps://www.alamyimages.fr/image-license-details/?v=1https://www.alamyimages.fr/vue-de-dessus-des-compte-gouttes-et-des-boites-de-petri-rondes-avec-des-echantillons-de-laboratoire-liquides-sur-une-surface-blanche-pendant-l-examen-microscopique-image487175275.htmlRF2K8GN0Y–Vue de dessus des compte-gouttes et des boîtes de Petri rondes avec des échantillons de laboratoire liquides sur une surface blanche pendant l'examen microscopique
RF2PHMC1G–Icône Vector Thick Line pour boîte de Pétri à usage personnel et commercial.
 Vecteur rond pointillé élément branchy Illustration de Vecteurhttps://www.alamyimages.fr/image-license-details/?v=1https://www.alamyimages.fr/vecteur-rond-pointille-element-branchy-image341971208.html
Vecteur rond pointillé élément branchy Illustration de Vecteurhttps://www.alamyimages.fr/image-license-details/?v=1https://www.alamyimages.fr/vecteur-rond-pointille-element-branchy-image341971208.htmlRF2ATA3NC–Vecteur rond pointillé élément branchy
 Boîte de Petri de vaccination . Illustration de Vecteurhttps://www.alamyimages.fr/image-license-details/?v=1https://www.alamyimages.fr/boite-de-petri-de-vaccination-image475438152.html
Boîte de Petri de vaccination . Illustration de Vecteurhttps://www.alamyimages.fr/image-license-details/?v=1https://www.alamyimages.fr/boite-de-petri-de-vaccination-image475438152.htmlRF2JHE260–Boîte de Petri de vaccination .
 Boîte de Pétri avec poudre de graphène, matériau léger, conducteur électrique, rigide et étanche. Banque D'Imageshttps://www.alamyimages.fr/image-license-details/?v=1https://www.alamyimages.fr/boite-de-petri-avec-poudre-de-graphene-materiau-leger-conducteur-electrique-rigide-et-etanche-image503424685.html
Boîte de Pétri avec poudre de graphène, matériau léger, conducteur électrique, rigide et étanche. Banque D'Imageshttps://www.alamyimages.fr/image-license-details/?v=1https://www.alamyimages.fr/boite-de-petri-avec-poudre-de-graphene-materiau-leger-conducteur-electrique-rigide-et-etanche-image503424685.htmlRF2M70Y91–Boîte de Pétri avec poudre de graphène, matériau léger, conducteur électrique, rigide et étanche.
 Boîte de Pétri avec échantillon isolé sur blanc Banque D'Imageshttps://www.alamyimages.fr/image-license-details/?v=1https://www.alamyimages.fr/boite-de-petri-avec-echantillon-isole-sur-blanc-image617413839.html
Boîte de Pétri avec échantillon isolé sur blanc Banque D'Imageshttps://www.alamyimages.fr/image-license-details/?v=1https://www.alamyimages.fr/boite-de-petri-avec-echantillon-isole-sur-blanc-image617413839.htmlRF2XTDHJ7–Boîte de Pétri avec échantillon isolé sur blanc
 métal rouillé, fragments de métal corrodés, dans une boîte de petri, étude de corrosion Banque D'Imageshttps://www.alamyimages.fr/image-license-details/?v=1https://www.alamyimages.fr/metal-rouille-fragments-de-metal-corrodes-dans-une-boite-de-petri-etude-de-corrosion-image703693131.html
métal rouillé, fragments de métal corrodés, dans une boîte de petri, étude de corrosion Banque D'Imageshttps://www.alamyimages.fr/image-license-details/?v=1https://www.alamyimages.fr/metal-rouille-fragments-de-metal-corrodes-dans-une-boite-de-petri-etude-de-corrosion-image703693131.htmlRF3CTRYNF–métal rouillé, fragments de métal corrodés, dans une boîte de petri, étude de corrosion
RF2XY1F78–La collection d'icônes de microbiologie est une illustration vectorielle avec trait modifiable.
 Résumé huile et eau de fond en noir et blanc Banque D'Imageshttps://www.alamyimages.fr/image-license-details/?v=1https://www.alamyimages.fr/resume-huile-et-eau-de-fond-en-noir-et-blanc-image417886885.html
Résumé huile et eau de fond en noir et blanc Banque D'Imageshttps://www.alamyimages.fr/image-license-details/?v=1https://www.alamyimages.fr/resume-huile-et-eau-de-fond-en-noir-et-blanc-image417886885.htmlRF2F7TAYH–Résumé huile et eau de fond en noir et blanc
 Motif de bâtons de contour sur fond blanc. Banque D'Imageshttps://www.alamyimages.fr/image-license-details/?v=1https://www.alamyimages.fr/motif-de-batons-de-contour-sur-fond-blanc-image359544733.html
Motif de bâtons de contour sur fond blanc. Banque D'Imageshttps://www.alamyimages.fr/image-license-details/?v=1https://www.alamyimages.fr/motif-de-batons-de-contour-sur-fond-blanc-image359544733.htmlRF2BTXJY9–Motif de bâtons de contour sur fond blanc.
 boîte de petri pour illustration vectorielle de recherche chimique et biologique isolée sur fond blanc Illustration de Vecteurhttps://www.alamyimages.fr/image-license-details/?v=1https://www.alamyimages.fr/boite-de-petri-pour-illustration-vectorielle-de-recherche-chimique-et-biologique-isolee-sur-fond-blanc-image609494559.html
boîte de petri pour illustration vectorielle de recherche chimique et biologique isolée sur fond blanc Illustration de Vecteurhttps://www.alamyimages.fr/image-license-details/?v=1https://www.alamyimages.fr/boite-de-petri-pour-illustration-vectorielle-de-recherche-chimique-et-biologique-isolee-sur-fond-blanc-image609494559.htmlRF2XBGTER–boîte de petri pour illustration vectorielle de recherche chimique et biologique isolée sur fond blanc
RF2C6TTRC–ensemble de 12 icônes de contour mince telles que le snot, la viande crue, la drogue, l'ambulance, la boîte de pétri, coronavirus pour le web, mobile
RF2DD62M5–Icône de glyphe noir de boîte de Pétri
RF2JAF69K–Illustration de l'oeddle chimique comprenant des icônes - flacon, tube de laboratoire, scientifique, compte-gouttes, boîte de Petri, bécher, expérience, éducation, biotechnologie. Fin
RF2T5A17R–Icône vectorielle représentant deux mains tenant une boîte de Pétri avec plusieurs points ou échantillons à l'intérieur. L'icône est entourée d'une bordure circulaire.
 Illustration du vecteur de concept abstrait de fécondation en tube à essai. Tube à essai bébé, fécondation in vitro, boîte de Petri, sélectionneur de plantes, inséminati artificiel Illustration de Vecteurhttps://www.alamyimages.fr/image-license-details/?v=1https://www.alamyimages.fr/illustration-du-vecteur-de-concept-abstrait-de-fecondation-en-tube-a-essai-tube-a-essai-bebe-fecondation-in-vitro-boite-de-petri-selectionneur-de-plantes-inseminati-artificiel-image467198267.html
Illustration du vecteur de concept abstrait de fécondation en tube à essai. Tube à essai bébé, fécondation in vitro, boîte de Petri, sélectionneur de plantes, inséminati artificiel Illustration de Vecteurhttps://www.alamyimages.fr/image-license-details/?v=1https://www.alamyimages.fr/illustration-du-vecteur-de-concept-abstrait-de-fecondation-en-tube-a-essai-tube-a-essai-bebe-fecondation-in-vitro-boite-de-petri-selectionneur-de-plantes-inseminati-artificiel-image467198267.htmlRF2J42M4B–Illustration du vecteur de concept abstrait de fécondation en tube à essai. Tube à essai bébé, fécondation in vitro, boîte de Petri, sélectionneur de plantes, inséminati artificiel
RF2C54Y81–boîte de pétri sang soins médicaux et hôpital pictogramme ligne style icône illustration vecteur
RF2H6459C–Ensemble d'icônes gris bactéries.Microbe, germe, cellule, caviar, système immunitaire et plus encore.
RF2B89H55–virus covid 19 pandémique pneumonie respiratoire icônes de maladie de définir vecteur illustration de style icône
 Des bactéries dans des boîtes de Pétri sur gélose dans le cadre d'expérience scientifique. Un plan macro noir et blanc. Banque D'Imageshttps://www.alamyimages.fr/image-license-details/?v=1https://www.alamyimages.fr/des-bacteries-dans-des-boites-de-petri-sur-gelose-dans-le-cadre-d-experience-scientifique-un-plan-macro-noir-et-blanc-image274536882.html
Des bactéries dans des boîtes de Pétri sur gélose dans le cadre d'expérience scientifique. Un plan macro noir et blanc. Banque D'Imageshttps://www.alamyimages.fr/image-license-details/?v=1https://www.alamyimages.fr/des-bacteries-dans-des-boites-de-petri-sur-gelose-dans-le-cadre-d-experience-scientifique-un-plan-macro-noir-et-blanc-image274536882.htmlRFWXJ6GJ–Des bactéries dans des boîtes de Pétri sur gélose dans le cadre d'expérience scientifique. Un plan macro noir et blanc.
 Ensemble simple. Développement et création de vaccins. Recherche clinique, anticorps, laboratoire, immunitaire, traitement, seringue. Vaccins à provention, lutte Illustration de Vecteurhttps://www.alamyimages.fr/image-license-details/?v=1https://www.alamyimages.fr/ensemble-simple-developpement-et-creation-de-vaccins-recherche-clinique-anticorps-laboratoire-immunitaire-traitement-seringue-vaccins-a-provention-lutte-image404018581.html
Ensemble simple. Développement et création de vaccins. Recherche clinique, anticorps, laboratoire, immunitaire, traitement, seringue. Vaccins à provention, lutte Illustration de Vecteurhttps://www.alamyimages.fr/image-license-details/?v=1https://www.alamyimages.fr/ensemble-simple-developpement-et-creation-de-vaccins-recherche-clinique-anticorps-laboratoire-immunitaire-traitement-seringue-vaccins-a-provention-lutte-image404018581.htmlRF2ED8HR1–Ensemble simple. Développement et création de vaccins. Recherche clinique, anticorps, laboratoire, immunitaire, traitement, seringue. Vaccins à provention, lutte
RFRACMG4–Ensemble d'icônes de ligne de vecteur de bactéries. Colonie de bactéries, virus, Pétri, la maladie, l'germe, microbe et plus encore.
 Contour noir de bactéries et de germes isolés dans une boîte de Pétri circulaire sur fond blanc, illustration graphique. concept de microbiologie, germes, patho Illustration de Vecteurhttps://www.alamyimages.fr/image-license-details/?v=1https://www.alamyimages.fr/contour-noir-de-bacteries-et-de-germes-isoles-dans-une-boite-de-petri-circulaire-sur-fond-blanc-illustration-graphique-concept-de-microbiologie-germes-patho-image685083129.html
Contour noir de bactéries et de germes isolés dans une boîte de Pétri circulaire sur fond blanc, illustration graphique. concept de microbiologie, germes, patho Illustration de Vecteurhttps://www.alamyimages.fr/image-license-details/?v=1https://www.alamyimages.fr/contour-noir-de-bacteries-et-de-germes-isoles-dans-une-boite-de-petri-circulaire-sur-fond-blanc-illustration-graphique-concept-de-microbiologie-germes-patho-image685083129.htmlRF3BPG6EH–Contour noir de bactéries et de germes isolés dans une boîte de Pétri circulaire sur fond blanc, illustration graphique. concept de microbiologie, germes, patho
 Le chlorure d'étain ou le chlorure stanneux est un solide cristallin blanc utilisé comme agent réducteur dans les solutions acides et dans les bains électrolytiques pour électroplat Banque D'Imageshttps://www.alamyimages.fr/image-license-details/?v=1https://www.alamyimages.fr/le-chlorure-d-etain-ou-le-chlorure-stanneux-est-un-solide-cristallin-blanc-utilise-comme-agent-reducteur-dans-les-solutions-acides-et-dans-les-bains-electrolytiques-pour-electroplat-image465554102.html
Le chlorure d'étain ou le chlorure stanneux est un solide cristallin blanc utilisé comme agent réducteur dans les solutions acides et dans les bains électrolytiques pour électroplat Banque D'Imageshttps://www.alamyimages.fr/image-license-details/?v=1https://www.alamyimages.fr/le-chlorure-d-etain-ou-le-chlorure-stanneux-est-un-solide-cristallin-blanc-utilise-comme-agent-reducteur-dans-les-solutions-acides-et-dans-les-bains-electrolytiques-pour-electroplat-image465554102.htmlRF2J1BR06–Le chlorure d'étain ou le chlorure stanneux est un solide cristallin blanc utilisé comme agent réducteur dans les solutions acides et dans les bains électrolytiques pour électroplat
 Boîte de Pétri avec échantillon isolé sur blanc Banque D'Imageshttps://www.alamyimages.fr/image-license-details/?v=1https://www.alamyimages.fr/boite-de-petri-avec-echantillon-isole-sur-blanc-image617728467.html
Boîte de Pétri avec échantillon isolé sur blanc Banque D'Imageshttps://www.alamyimages.fr/image-license-details/?v=1https://www.alamyimages.fr/boite-de-petri-avec-echantillon-isole-sur-blanc-image617728467.htmlRF2XTYXXY–Boîte de Pétri avec échantillon isolé sur blanc
 tube à essai Banque D'Imageshttps://www.alamyimages.fr/image-license-details/?v=1https://www.alamyimages.fr/photo-image-tube-a-essai-172066150.html
tube à essai Banque D'Imageshttps://www.alamyimages.fr/image-license-details/?v=1https://www.alamyimages.fr/photo-image-tube-a-essai-172066150.htmlRFKYX83J–tube à essai
 Boîte de Pétri avec liquide isolé sur blanc Banque D'Imageshttps://www.alamyimages.fr/image-license-details/?v=1https://www.alamyimages.fr/boite-de-petri-avec-liquide-isole-sur-blanc-image547724125.html
Boîte de Pétri avec liquide isolé sur blanc Banque D'Imageshttps://www.alamyimages.fr/image-license-details/?v=1https://www.alamyimages.fr/boite-de-petri-avec-liquide-isole-sur-blanc-image547724125.htmlRF2PR2YKW–Boîte de Pétri avec liquide isolé sur blanc
RF2XXXTK4–La collection d'icônes de microbiologie est une illustration vectorielle avec trait modifiable.
 Boîte de Petri avec échantillon isolé sur blanc, vue de dessus Banque D'Imageshttps://www.alamyimages.fr/image-license-details/?v=1https://www.alamyimages.fr/boite-de-petri-avec-echantillon-isole-sur-blanc-vue-de-dessus-image617890140.html
Boîte de Petri avec échantillon isolé sur blanc, vue de dessus Banque D'Imageshttps://www.alamyimages.fr/image-license-details/?v=1https://www.alamyimages.fr/boite-de-petri-avec-echantillon-isole-sur-blanc-vue-de-dessus-image617890140.htmlRF2XW7950–Boîte de Petri avec échantillon isolé sur blanc, vue de dessus
RF2BTT50T–boîte de pétri avec icône bactérias sur fond blanc, style de ligne, illustration vectorielle
 Boîte de Pétri avec liquide sur fond blanc, vue de dessus Banque D'Imageshttps://www.alamyimages.fr/image-license-details/?v=1https://www.alamyimages.fr/boite-de-petri-avec-liquide-sur-fond-blanc-vue-de-dessus-image547724161.html
Boîte de Pétri avec liquide sur fond blanc, vue de dessus Banque D'Imageshttps://www.alamyimages.fr/image-license-details/?v=1https://www.alamyimages.fr/boite-de-petri-avec-liquide-sur-fond-blanc-vue-de-dessus-image547724161.htmlRF2PR2YN5–Boîte de Pétri avec liquide sur fond blanc, vue de dessus
RF2DDP6B7–Icône blanche de la craie pour boîte de Pétri sur fond noir
RF2C6TTG7–ensemble de 12 icônes de contour mince comme éternuer, quarantaine, pandémie, masque médical, boîte de petri, médecin pour le web, mobile
RF2CTT2PC–boîte de pétri avec icône du virus coronavirus sur fond blanc, style de trait, illustration vectorielle
 Myxomycète jaune (Physarum polycephalum) croissant et Réseau formant dans Agar Pétri. Projet de laboratoire de biologie, en Écosse, au Royaume-Uni. Banque D'Imageshttps://www.alamyimages.fr/image-license-details/?v=1https://www.alamyimages.fr/myxomycete-jaune-physarum-polycephalum-croissant-et-reseau-formant-dans-agar-petri-projet-de-laboratoire-de-biologie-en-ecosse-au-royaume-uni-image225941126.html
Myxomycète jaune (Physarum polycephalum) croissant et Réseau formant dans Agar Pétri. Projet de laboratoire de biologie, en Écosse, au Royaume-Uni. Banque D'Imageshttps://www.alamyimages.fr/image-license-details/?v=1https://www.alamyimages.fr/myxomycete-jaune-physarum-polycephalum-croissant-et-reseau-formant-dans-agar-petri-projet-de-laboratoire-de-biologie-en-ecosse-au-royaume-uni-image225941126.htmlRFR3GE5X–Myxomycète jaune (Physarum polycephalum) croissant et Réseau formant dans Agar Pétri. Projet de laboratoire de biologie, en Écosse, au Royaume-Uni.
RF2HJ2M2J–Icône de boîte de Petri plate.Pictogramme pour le Web.Trait.Isolé sur fond blanc.Icônes de chimie vecteur eps10
 Laboratoire naturel en noir et blanc.Arrangement floral abstrait avec des feuilles de monstère exotiques dans des vases en verre transparent, des bocaux, des flacons.Réflexions Banque D'Imageshttps://www.alamyimages.fr/image-license-details/?v=1https://www.alamyimages.fr/laboratoire-naturel-en-noir-et-blanc-arrangement-floral-abstrait-avec-des-feuilles-de-monstere-exotiques-dans-des-vases-en-verre-transparent-des-bocaux-des-flacons-reflexions-image449392402.html
Laboratoire naturel en noir et blanc.Arrangement floral abstrait avec des feuilles de monstère exotiques dans des vases en verre transparent, des bocaux, des flacons.Réflexions Banque D'Imageshttps://www.alamyimages.fr/image-license-details/?v=1https://www.alamyimages.fr/laboratoire-naturel-en-noir-et-blanc-arrangement-floral-abstrait-avec-des-feuilles-de-monstere-exotiques-dans-des-vases-en-verre-transparent-des-bocaux-des-flacons-reflexions-image449392402.htmlRF2H33GGJ–Laboratoire naturel en noir et blanc.Arrangement floral abstrait avec des feuilles de monstère exotiques dans des vases en verre transparent, des bocaux, des flacons.Réflexions
RF2B896MA–virus covid 19 pandémique pneumonie respiratoire icônes de maladie de définir vecteur illustration de style icône
 Des bactéries dans des boîtes de Pétri sur gélose dans le cadre d'expérience scientifique. Un plan macro noir et blanc. Banque D'Imageshttps://www.alamyimages.fr/image-license-details/?v=1https://www.alamyimages.fr/des-bacteries-dans-des-boites-de-petri-sur-gelose-dans-le-cadre-d-experience-scientifique-un-plan-macro-noir-et-blanc-image269347439.html
Des bactéries dans des boîtes de Pétri sur gélose dans le cadre d'expérience scientifique. Un plan macro noir et blanc. Banque D'Imageshttps://www.alamyimages.fr/image-license-details/?v=1https://www.alamyimages.fr/des-bacteries-dans-des-boites-de-petri-sur-gelose-dans-le-cadre-d-experience-scientifique-un-plan-macro-noir-et-blanc-image269347439.htmlRFWJ5RBB–Des bactéries dans des boîtes de Pétri sur gélose dans le cadre d'expérience scientifique. Un plan macro noir et blanc.
RF2EN8WJD–laboratoire, jeu d'icônes de la salle de laboratoire, vecteur et illustration
RF2JG18JG–Illustration de la composition chimique avec icônes plates : flacon, tube de laboratoire, scientifique, propulseur, boîte de Petri, bécher, expérience, biotechnologie. Glyphe
RF2EN95D5–transmission de virus,coronavirus,covid19 jeu d'icônes,vecteur et illustration
RF2JGAPYJ–icône boîte de pétri. Simple ligne fine, vectorisation des icônes de biologie pour UI et UX, site Web ou application mobile sur fond blanc
RF2EA1C3R–laboratoire,icône de ligne scientifique,tracé modifiable,icône pixel perfect
 Boîtes de Petri avec liquide transparent sur fond blanc Banque D'Imageshttps://www.alamyimages.fr/image-license-details/?v=1https://www.alamyimages.fr/boites-de-petri-avec-liquide-transparent-sur-fond-blanc-image703543116.html
Boîtes de Petri avec liquide transparent sur fond blanc Banque D'Imageshttps://www.alamyimages.fr/image-license-details/?v=1https://www.alamyimages.fr/boites-de-petri-avec-liquide-transparent-sur-fond-blanc-image703543116.htmlRF3CTH4BT–Boîtes de Petri avec liquide transparent sur fond blanc
 Boîtes de Petri isolées, plat de laboratoire en biologie du verre sur fond transparent Illustration de Vecteurhttps://www.alamyimages.fr/image-license-details/?v=1https://www.alamyimages.fr/boites-de-petri-isolees-plat-de-laboratoire-en-biologie-du-verre-sur-fond-transparent-image342339967.html
Boîtes de Petri isolées, plat de laboratoire en biologie du verre sur fond transparent Illustration de Vecteurhttps://www.alamyimages.fr/image-license-details/?v=1https://www.alamyimages.fr/boites-de-petri-isolees-plat-de-laboratoire-en-biologie-du-verre-sur-fond-transparent-image342339967.htmlRF2ATXX3B–Boîtes de Petri isolées, plat de laboratoire en biologie du verre sur fond transparent
RF2XY2F84–La collection d'icônes de recherche et développement est une illustration vectorielle avec trait modifiable.
 Microscope et mains en laboratoire porter des gants wb Banque D'Imageshttps://www.alamyimages.fr/image-license-details/?v=1https://www.alamyimages.fr/microscope-et-mains-en-laboratoire-porter-des-gants-wb-image401351069.html
Microscope et mains en laboratoire porter des gants wb Banque D'Imageshttps://www.alamyimages.fr/image-license-details/?v=1https://www.alamyimages.fr/microscope-et-mains-en-laboratoire-porter-des-gants-wb-image401351069.htmlRF2E8Y3AN–Microscope et mains en laboratoire porter des gants wb
 bromure de lithium, composé chimique de brome et de lithium extrêmement hygroscopique et utilisé comme dessiccant dans les systèmes de climatisation Banque D'Imageshttps://www.alamyimages.fr/image-license-details/?v=1https://www.alamyimages.fr/bromure-de-lithium-compose-chimique-de-brome-et-de-lithium-extremement-hygroscopique-et-utilise-comme-dessiccant-dans-les-systemes-de-climatisation-image485043414.html
bromure de lithium, composé chimique de brome et de lithium extrêmement hygroscopique et utilisé comme dessiccant dans les systèmes de climatisation Banque D'Imageshttps://www.alamyimages.fr/image-license-details/?v=1https://www.alamyimages.fr/bromure-de-lithium-compose-chimique-de-brome-et-de-lithium-extremement-hygroscopique-et-utilise-comme-dessiccant-dans-les-systemes-de-climatisation-image485043414.htmlRF2K53HR2–bromure de lithium, composé chimique de brome et de lithium extrêmement hygroscopique et utilisé comme dessiccant dans les systèmes de climatisation